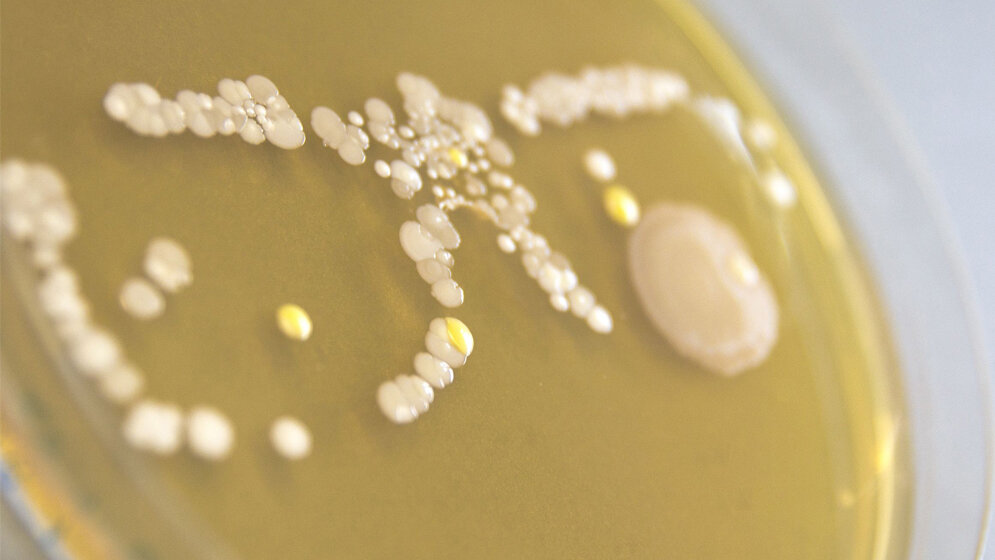
Bakterielle_Besiedlung_der_Rahmen_der_Brille_zeichnet_sich_ab_Theresa_Muehlbauer.jpg Bakterielle Besiedlung

Eine Studie untersucht nun erstmals umfassend die Mikroflora von Brillen. Der Studienleiter ist der Mikrobiologe Prof. Dr. Markus Egert von der Hochschule Furtwangen, der bekannt ist für seine Untersuchungen zur Keimbelastung von Küchenschwämmen und anderen Gebrauchsgegenständen.
Bisher keine wissenschaftlichen Erkenntnisse
Im Jahr 2018 gab es in der deutschsprachigen Bevölkerung ab 14 Jahren rund 44,2 Millionen Personen, die ständig oder gelegentlich eine Brille trugen. Es gibt zwar Untersuchungen über die Keimbelastung von Brillen für Chirurgen oder für 3D-Brillen, welche in Kinos verliehen werden, doch zu den ganz regulären Brillen für Alt und Jung fehlten bislang die wissenschaftlichen Erkenntnisse. Für die Studie wurden insgesamt 31 Brillen an je sieben Stellen (Rahmen, Nasenpolster, Gläser) mit Tupfern beprobt und nach der Anzucht auf Nährmedien die vorhandenen Bakterien untersucht. 21 Brillen stammten von Studierenden und Mitarbeitern der Hochschule Furtwangen, zehn von Bewohnern eines Altenheims. „Alle untersuchten Brillen waren bakteriell besiedelt“, erläutert Prof. Dr. Markus Egert. „Am stärksten an Stellen mit direktem Hautkontakt wie Ohrbügel und Nasenpolster. Die geringste Keimdichte fand sich auf den Gläsern.“ Gemessener Spitzenwert waren 660.000 Bakterien/cm2 auf einem Nasenpolster.
Höhere Vielfalt bei Altenheim-Brillen
Im Mittel über alle Stellen waren die Hochschul-Brillen nicht stärker besiedelt als die Altenheim-Brillen: 1.400 im Gegensatz zu 2.080 Bakterien/cm2. Auf den Gläsern der Altenheim-Brillen wurden aber deutlich mehr Bakterien als auf den Hochschul-Brillen nachgewiesen (230 Bakterien/cm2 gegenüber 40 Bakterien/cm2). Eine mögliche Erklärung dafür: Die altersbedingte Sehschwäche der Seniorenheimbewohner fördert die Verkeimung der Gläser, weil sie diese seltener reinigen, denn Fingerabdrücke oder ähnliche Verschmutzungen auf den Gläsern fallen ihnen weniger auf. Auf den Altenheim-Brillen zeigte sich zudem eine höhere Vielfalt an Bakterien (zehn Gattungen im Gegensatz zu zwei Gattungen auf den Hochschul-Brillen). Dazu passt: Auch die Hautflora wird mit zunehmendem Alter vielfältiger.
Auch potentiell pathogene Bakterien
Identifiziert wurden vor allem typische Haut- und Schleimhautbakterien, vor allem der Gattung Staphylococcus. Der Anteil an potentiell pathogenen, also potentiell gesundheitsschädlichen Bakterienarten lag bei rund 60%. Diese Bakterien können vor allem bei Menschen mit einem geschwächten Immunsystem Krankheiten auslösen. Es wurden auch Auslöser von Augenerkrankungen wie Bindehautentzündung oder Endophthalmitis gefunden, etwa Staphylococcus epidermidis, Staphylococcus hominis und Staphylococcus aureus. Von diesen Arten sind auch Antibiotika-resistente Varianten bekannt.
Mit standardisierten Reinigungs-Tests wurde schließlich gezeigt, dass sich durch Abreiben von Gläsern und kompletten Brillen mit feuchten Brillen-Reinigungstüchern eine Keimreduktion um 94 - 99% erreichen lässt. Dabei wurden auch Reinigungstücher mit einer alkoholfreien Reinigungslösung getestet, die schonender zu Gestellen aus Kunststoff ist. Eine trockene Reinigung war weniger effektiv beim Entfernen von Keimen und erzielte 85 - 90% Reduktion.
Zusammenhang zu Augeninfektionen?
„Die Studie zeigt deutlich, dass Brillen als Keimträger fungieren“, wertet Prof. Dr. Markus Egert. In weiteren Studien soll gezeigt werden, ob Zusammenhänge zwischen der Brillenflora und wiederkehrenden Augeninfektionen bestehen können, also ob eine Brille als eine Art Erreger-Reservoir fungieren kann. Weiterhin soll untersucht werden, ob Brillen auch Verstecke für Antibiotika-resistente Keime wie MRSA (Multi-resistenter Staphylococcus aureus) sein können, insbesondere im klinischen Umfeld.
„Für gesunde Menschen stellt ihre Brille sicher kein besonderes Infektionsrisiko dar“, beruhigt Prof. Dr. Markus Egert. „Bei häufig wiederkehrenden Augeninfekten oder einer nötigen MRSA-Sanierung sollte aber auch an eine Desinfektion der Brille gedacht werden.“
Forschungsprojekt: Kooperationsprojekt der Hochschule Furtwangen mit der Carl Zeiss Vision International GmbH (Aalen), der Universitäts-Augenklinik Tübingen und den Laborärzten Singen im Rahmen des vom Bundesministerium für Bildung und Forschung geförderten Projektes CoHMed (Connected Health in Medical Mountains), mit dem die Kooperation zwischen der Hochschule Furtwangen und der regionalen Medizintechnik-Industrie gefördert wird. (idw, red)
Birgit Fritz, Anne Jenner, Siegfried Wahl, et al.: A view to a kill? – Ambient bacterial load of frames and lenses of spectacles and evaluation of different cleaning methods. PLOS One, published: November 28, 2018, doi.org/10.1371/journal.pone.0207238.
Artikel teilen